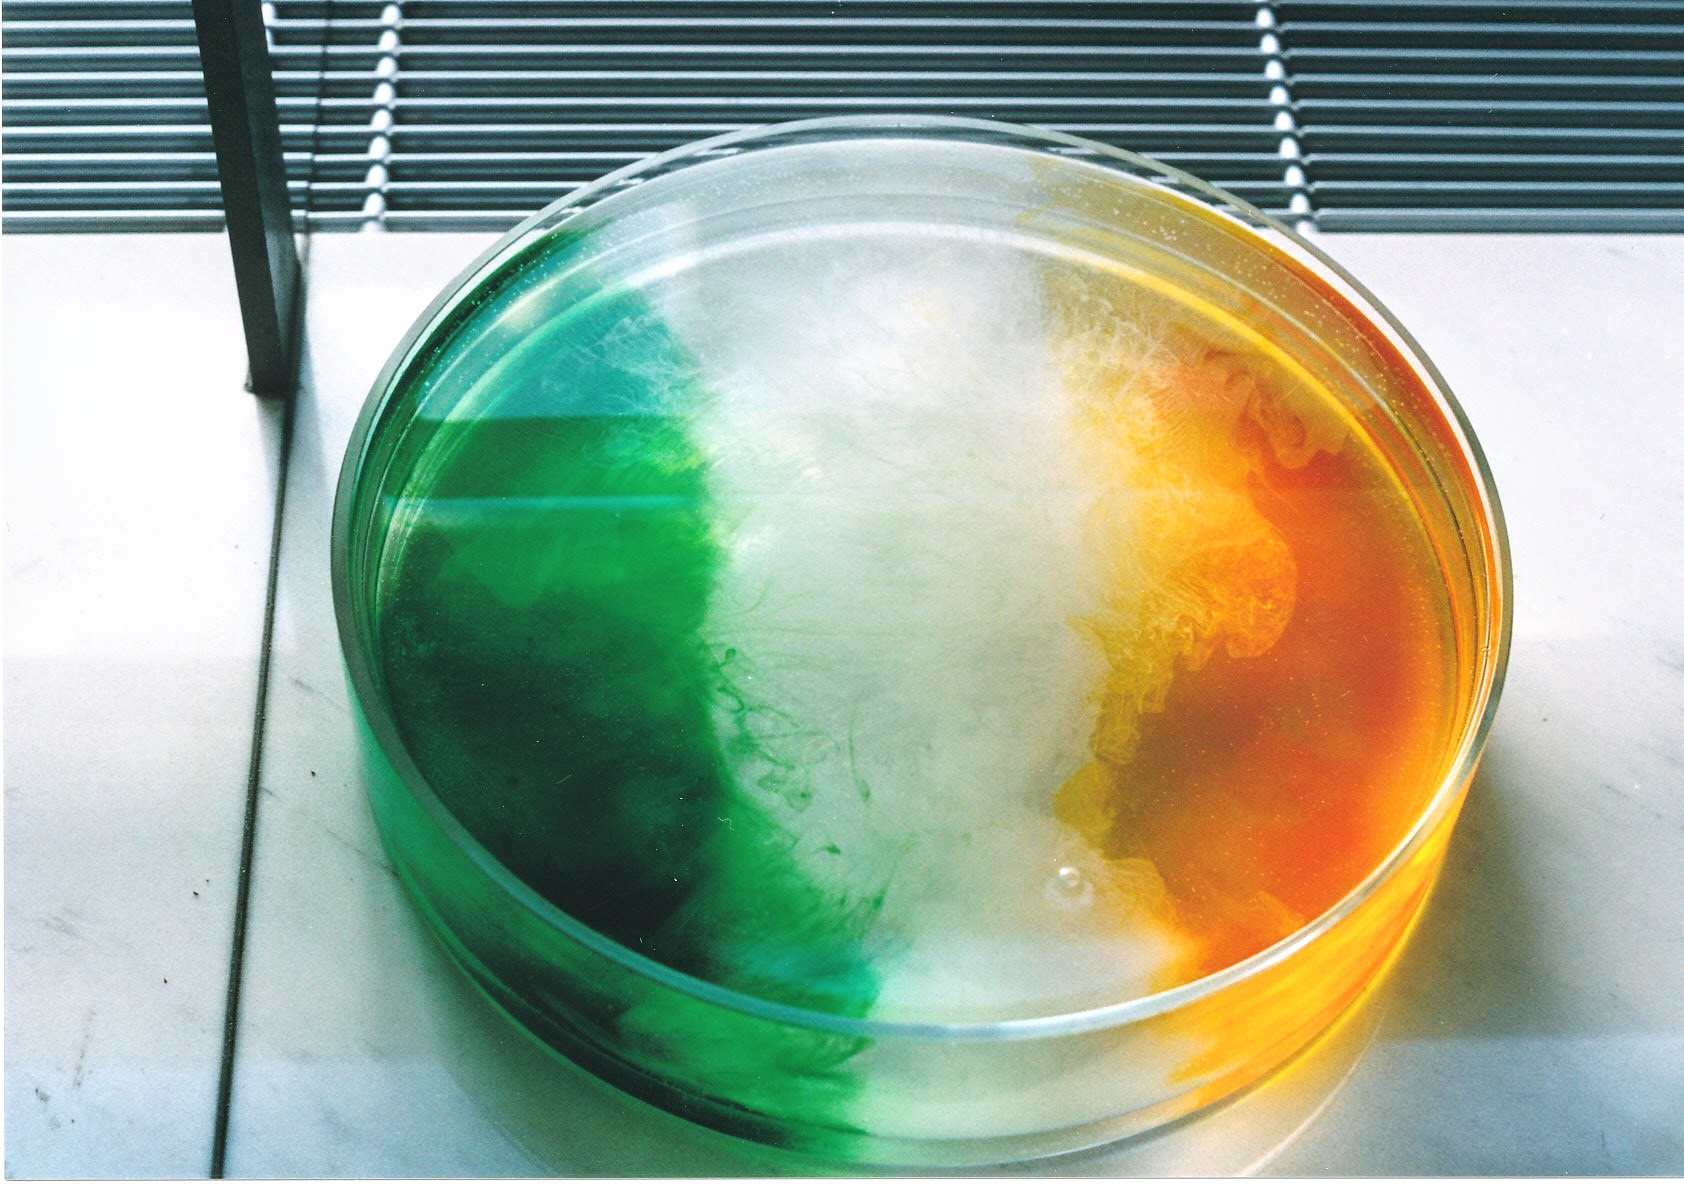

Conjuring a volcanic eruption 2000
In February year 2000 artists from all the Cultural Cities of Europe were invited to exhibit and perform their art live at the European Parliament. I was the artist representing Reykjavik. A block of Icelandic lava was suspended at eye level above 3 large blocks of ice floating in a metal box. The lava was melted with blowtorch and dripped in fine threads onto the ice where it transformed into black glass. The volcanic nature of the stone was reactivated as the primary elements of Iceland were unleashed. Incredibly just as this performance was taken place the infamous Hekla, Iceland´s most active volcano awoke from her slumber and erupted. This served as an apt reminder that in the face of nature´s power man´s work is all but insignificant.
25/2/2000
-
26/2/2000
The European Parliament, Brussels, Belgium



.jpg)